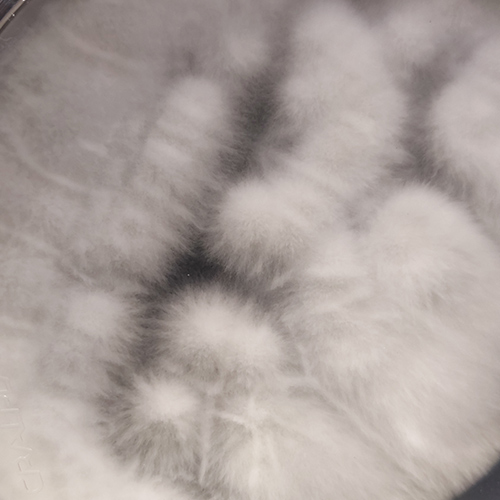
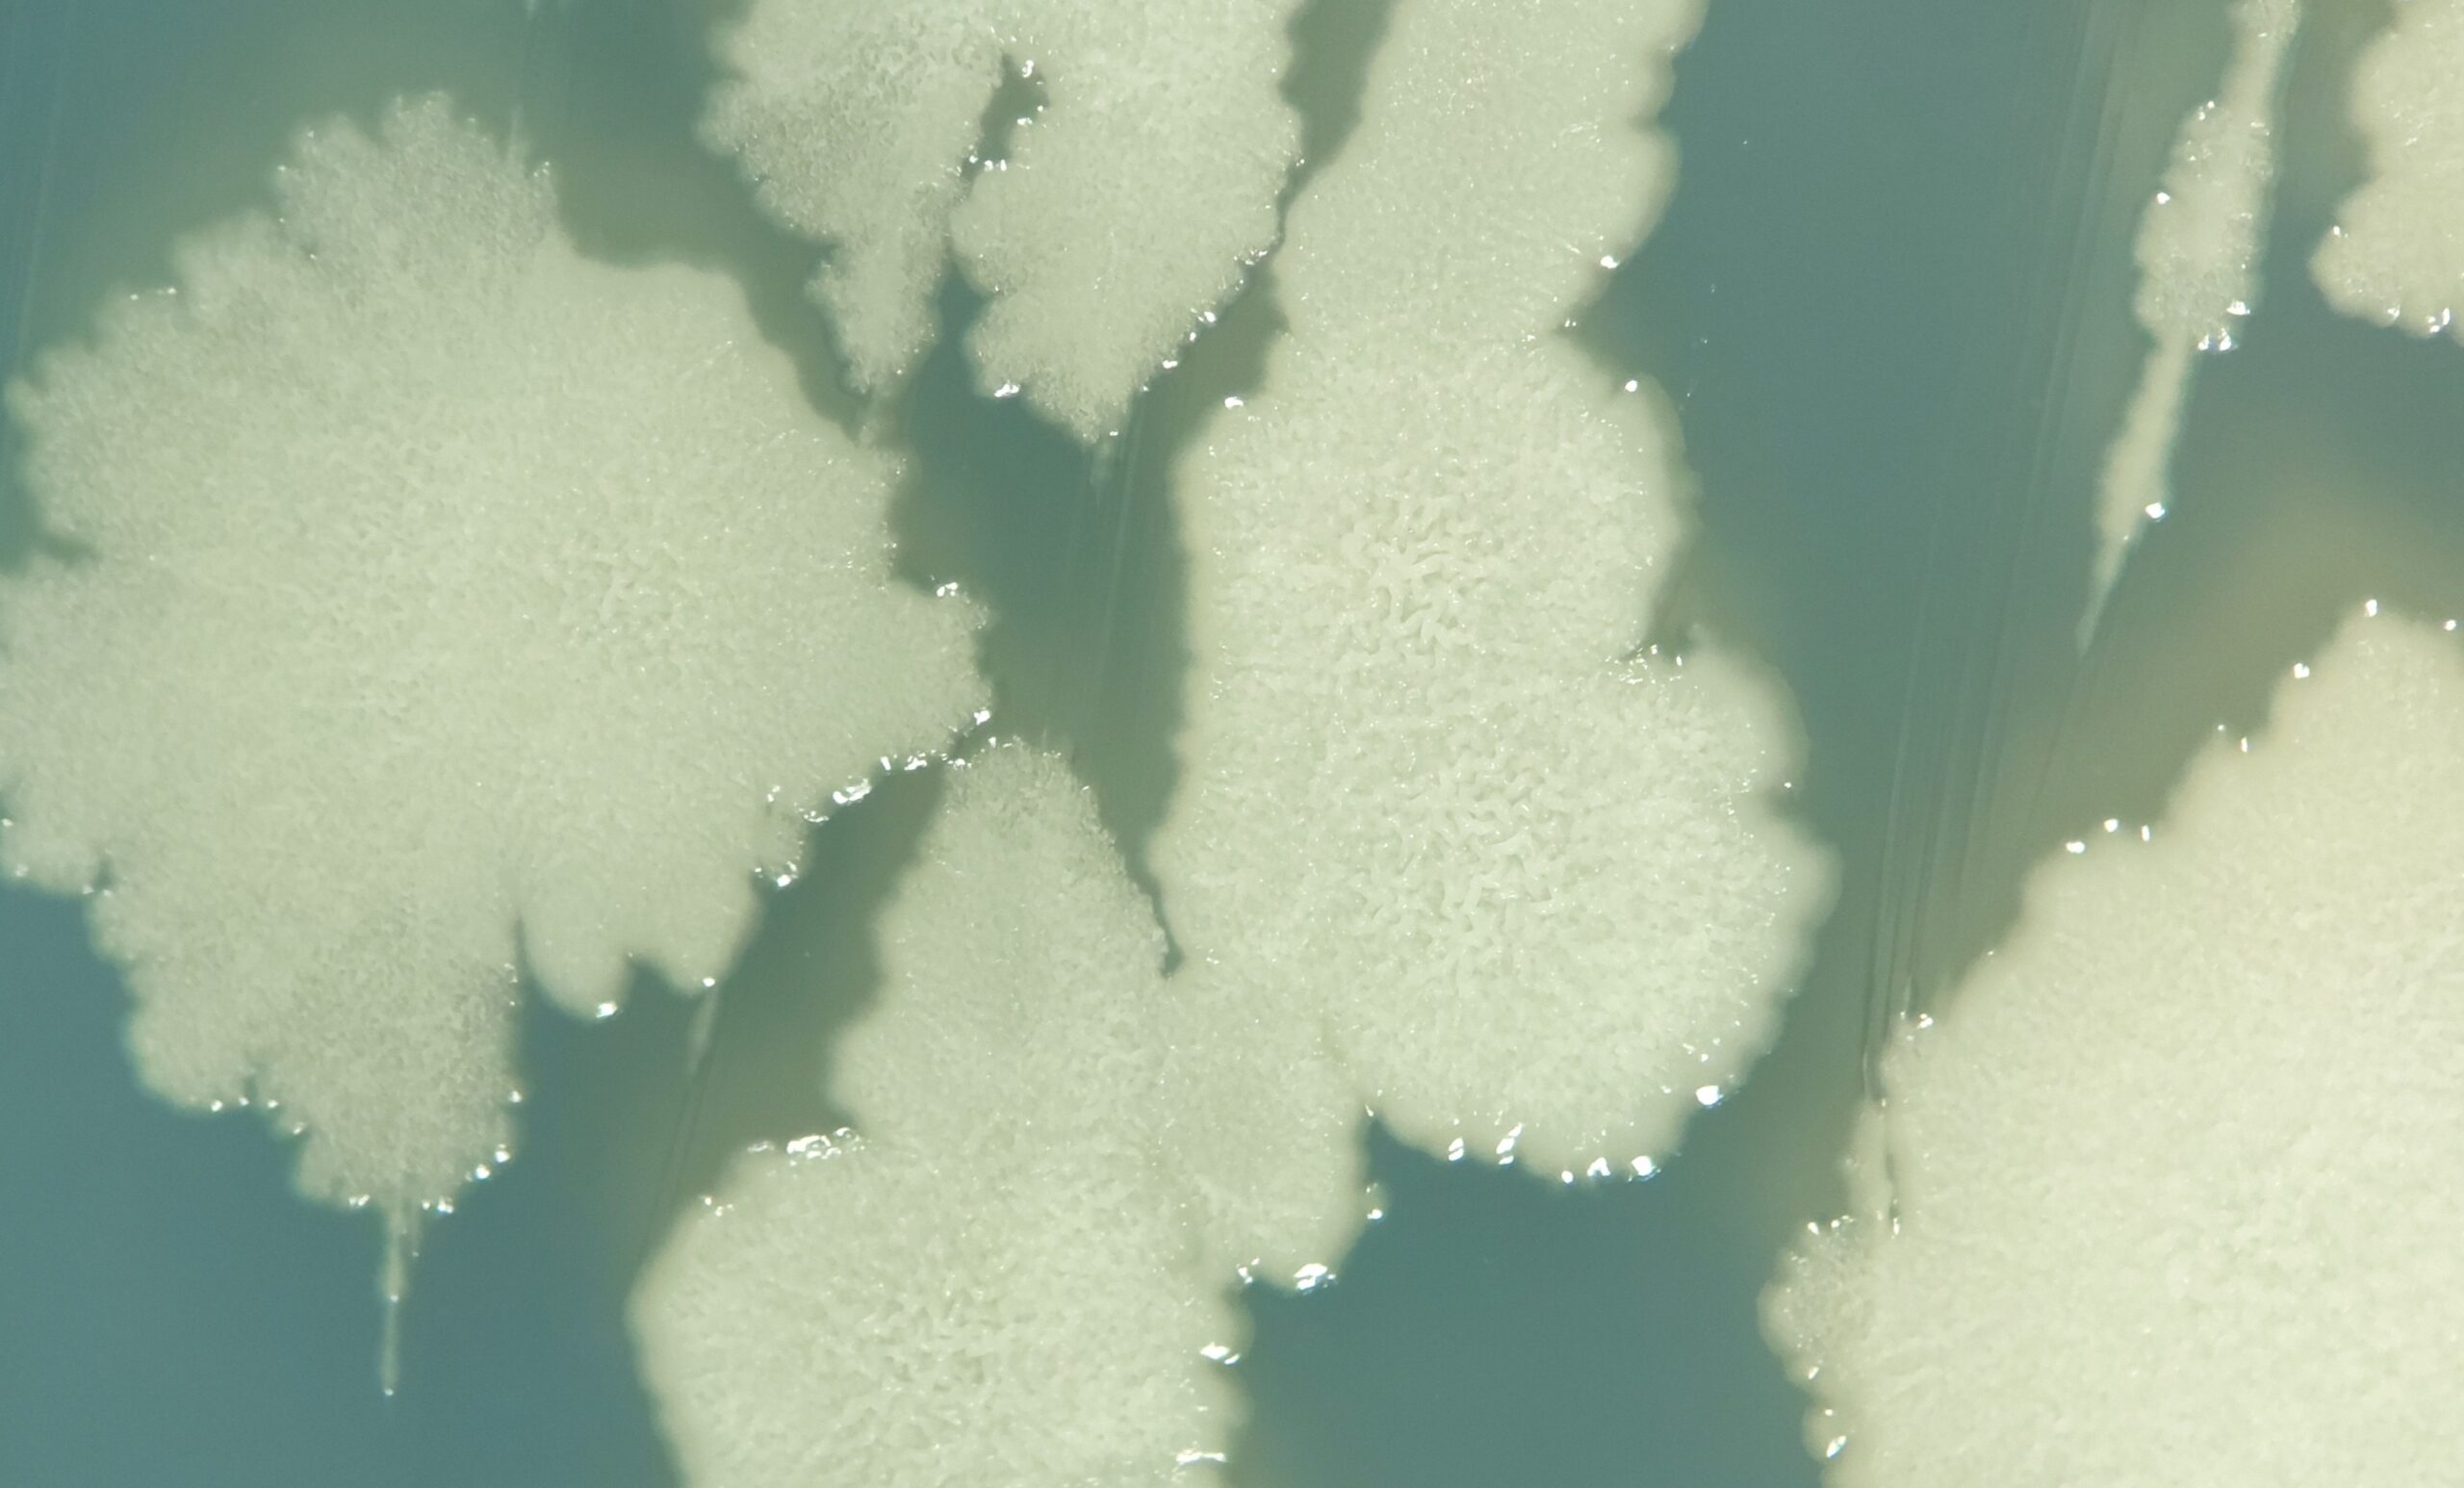
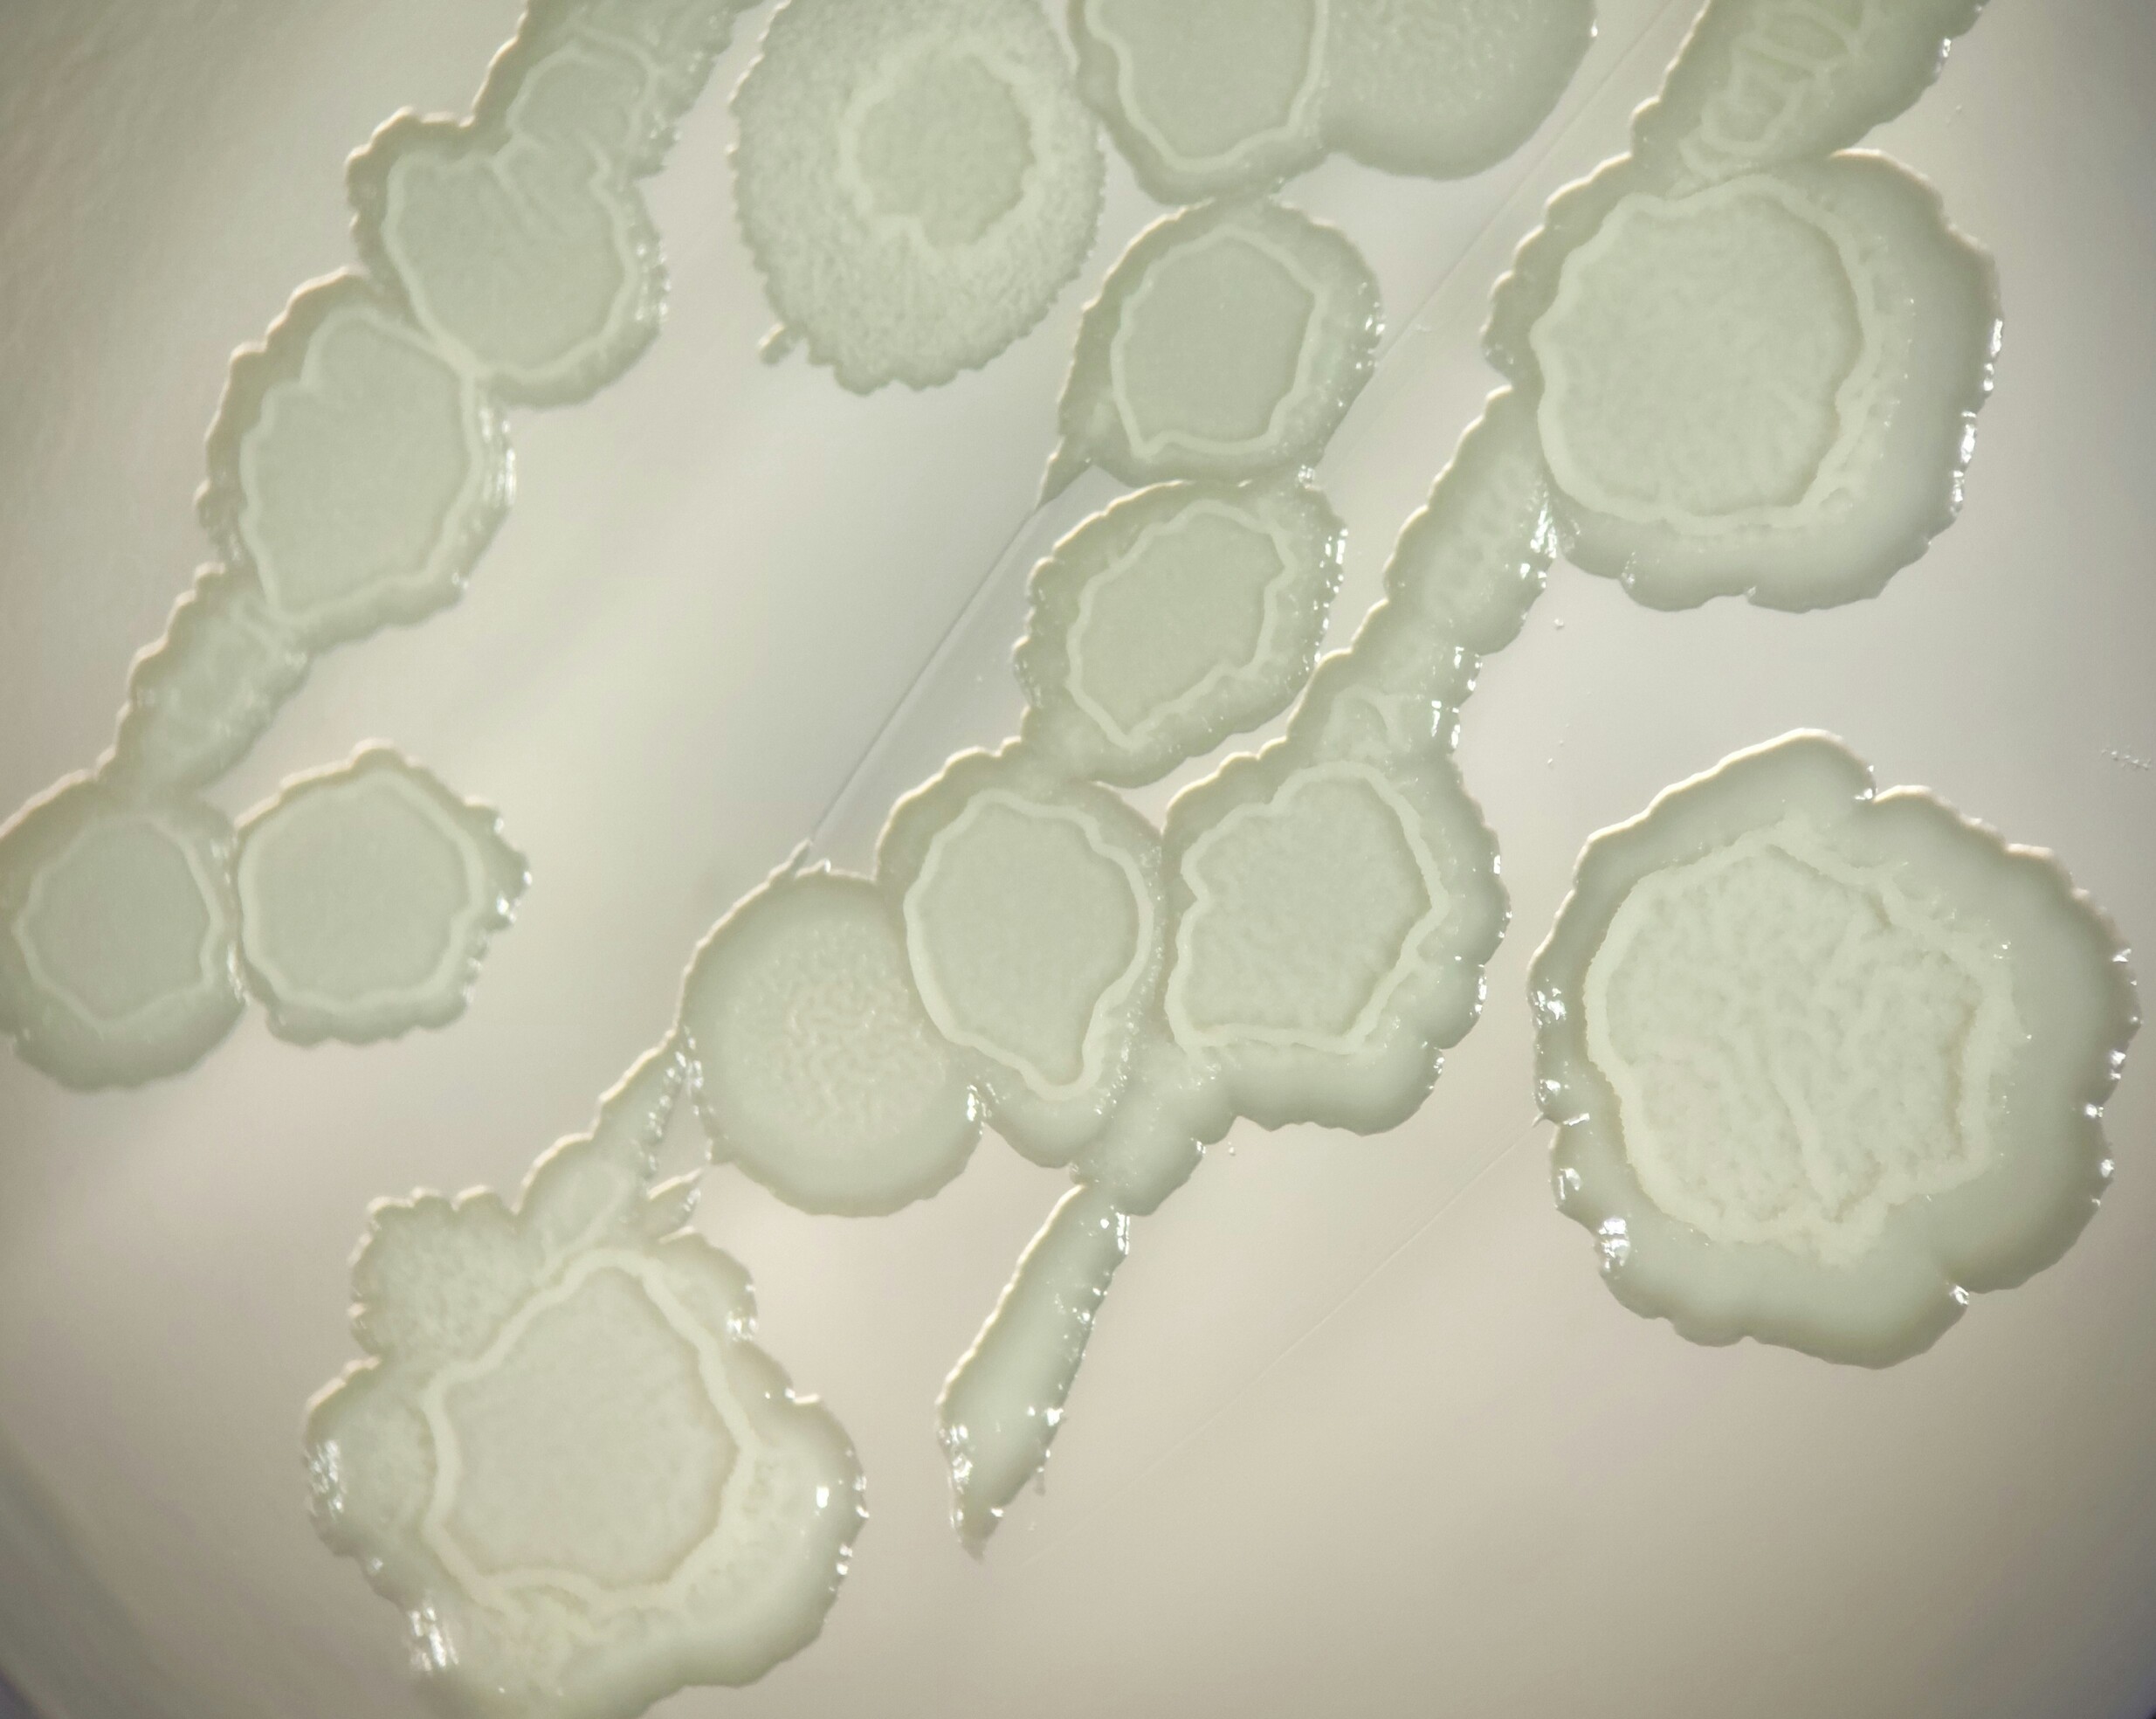

O Brasil é referência mundial na cultura do café, com uma diversidade única de variedades, altitudes e microclimas. Esse cenário demanda soluções que respeitem as particularidades de cada lavoura.
Na Vittia, oferecemos soluções integradas que acompanham todas as etapas do ciclo da cultura do café, atendendo às suas exigências específicas. Nossos produtos contribuem para o desempenho da lavoura por meio de tecnologias avançadas em nutrição, controle biológico e manejo integrado de pragas e doenças.
Principais produtos
Confira abaixo os produtos relacionados